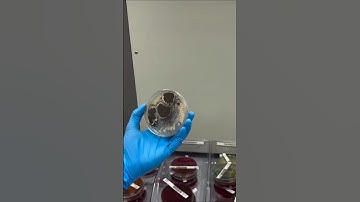
Microbiology #laboratory #science #laboratorytechniques #labtechnition #lab #microbiology #shorts

⬇ DOWNLOAD NOW
Kalau muncul iklan pop-up, tutup lalu klik tombol kembali
Download lagu #laboratory #science #labtechnition #laboratorytechniques #lab #science #microbiology secara gratis hanya untuk keperluan promosi. Dukung artis favorit kamu dengan membeli musik original di iTunes atau platform resmi lainnya.
 Insight into a Microbiology Lab
Insight into a Microbiology Lab
 Medical Laboratory Week
Medical Laboratory Week
 SCIENCE Laboratory Technology
SCIENCE Laboratory Technology
 Day in the Life of a Medical Laboratory Technician
Day in the Life of a Medical Laboratory Technician
 Microbiology 🦠 #laboratory #science #laboratorytechniques #labtechnition #lab #microbiology #shorts
Microbiology 🦠 #laboratory #science #laboratorytechniques #labtechnition #lab #microbiology #shorts
 Dalena Nguyen - Clinical Laboratory Technologist, Mayo Clinic
Dalena Nguyen - Clinical Laboratory Technologist, Mayo Clinic
 A day in the life of a Medical Laboratory Technician
A day in the life of a Medical Laboratory Technician
Microbiology #laboratory #science #laboratorytechniques #labtechnition #lab #microbiology #shorts
Microbiology #laboratory #science #laboratorytechniques #labtechnition #lab #microbiology #shorts